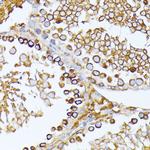
CAD Antibody in Immunohistochemistry (Paraffin) (IHC (P))

Search
Invitrogen
CAD Polyclonal Antibody
{{$productOrderCtrl.translations['antibody.pdp.commerceCard.promotion.promotions']}}
{{$productOrderCtrl.translations['antibody.pdp.commerceCard.promotion.viewpromo']}}
{{$productOrderCtrl.translations['antibody.pdp.commerceCard.promotion.promocode']}}: {{promo.promoCode}} {{promo.promoTitle}} {{promo.promoDescription}}. {{$productOrderCtrl.translations['antibody.pdp.commerceCard.promotion.learnmore']}}

Please note: We are reviewing Western blot images included in the antibody testing data in our catalog, including those provided by third parties. Unless expressly labeled or annotated as “raw-unedited”, Western blot images included in the antibody testing data in our catalog may have been edited, optimized or otherwise adjusted for presentation.
产品信息
PA5-97015
种属反应
宿主/亚型
分类
类型
抗原
偶联物
形式
浓度
规格
纯化类型
保存液
内含物
保存条件
运输条件
RRID
产品详细信息
Immunogen sequence: LERLGPGKGE VRPELGSRQD VEALWENMAV IDCFASDHAP HTLEEKCGSR PPPGFPGLET MLPLLLTAVS EGRLSLDDLL QRLHHNPRRI FHLPPQEDTY VEVDLEHEWT IPSHMPFSKA HWTPFEGQKV KGTVRRVVLR GEVAYIDGQV LVPPGYGQDV RKWPQGAVPQ LPPSAPATSE MTTTPERPRR GIPGLPDGRF HLPPRIHRAS DPGLPAEEPK EKSSRKVAEP ELMGTPDGTC YPPPPVPRQA S; Positive Samples: SW620, HepG2, HeLa, HL-60; Cellular Location: Cytoplasm, Nucleus
靶标信息
The de novo synthesis of pyrimidine nucleotides is required for mammalian cells to proliferate. This gene encodes a trifunctional protein which is associated with the enzymatic activities of the first 3 enzymes in the 6-step pathway of pyrimidine biosynthesis: carbamoylphosphate synthetase (CPS II), aspartate transcarbamoylase, and dihydroorotase. This protein is regulated by the mitogen-activated protein kinase (MAPK) cascade, which indicates a direct link between activation of the MAPK cascade and de novo biosynthesis of pyrimidine nucleotides.
仅用于科研。不用于诊断过程。未经明确授权不得转售。
篇参考文献 (0)
生物信息学
蛋白别名: CAD protein; CAD trifunctional protein; Carbamoyl phosphate synthetase 2-aspartate transcarbamylase-dihydroorotase; carbamyl phosphatate synthetase 2; Multifunctional protein CAD
基因别名: 2410008J01Rik; AU018859; CAD; CDG1Z; Cpad; DEE50; EIEE50; GATD4
UniProt ID: (Mouse) B2RQC6
Entrez Gene ID: (Human) 790, (Mouse) 69719, (Rat) 24240




